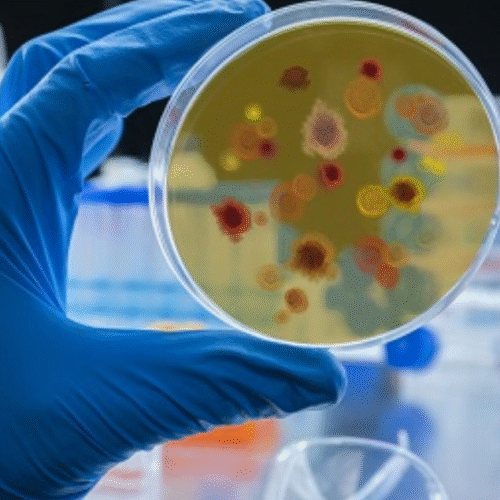
Proa Medicamentos

Con el fin de proteger la salud de las y los bogotanos durante esta temporada de Fin de Año, la Secretaría Distrital de Salud desplegará 285 operativos de inspección, vigilancia y control para garantizar que los alimentos, bebidas y juguetes que se comercializan en el distrito sean seguros y cumplan con la normativa sanitaria.
Categoría: 2. Noticias superior
La Subred Sur continúa acercando servicios de salud a las comunidades del sur de Bogotá
La Subred Integrada de Servicios de Salud Sur mantiene su compromiso de acercar la atención a los territorios y garantizar el acceso oportuno de las comunidades.
Subred Sur y Alcaldía Local de Ciudad Bolívar cierran estrategia de Terapia Asistida
La Subred Sur, en articulación con la alcaldía local de Ciudad Bolívar, llevó a cabo el cierre oficial de la estrategia de Terapia Asistida con Animales (Equinoterapia).
Bogotá se une a la Concientización sobre la Resistencia a los Antimicrobianos
Bajo el lema ‘Actuemos ya: protejamos nuestro presente, aseguremos nuestro futuro’, la Secretaría Distrital de Salud (SDS) liderará en Bogotá la Semana Mundial de Concientización sobre la Resistencia a los Antimicrobianos (RAM), del 18 al 24 de noviembre.
Una mirada a la salud y el bienestar: Bogotá actúa para prevenir la diabetes y cuidar la visión
La diabetes y sus complicaciones representan hoy uno de los principales desafíos para la salud pública de Bogotá.
Comunicado a la opinión pública
La Subred Integrada de Servicios de Salud Centro Oriente E.S.E. informa que los tres pacientes involucrados en el siniestro vial ocurrido el pasado sábado en la localidad de San Cristóbal continúan recibiendo atención especializada e integral.
Bogotá fortalece la educación alimentaria con el simposio ‘Sabores que nutren’
Entre aromas frescos, recetas tradicionales y reflexiones profundas, la Secretaría Distrital de Salud realizó el Simposio Distrital de Educación Alimentaria y Nutricional 2025 ‘Sabores que nutren’.
Espacios urbanos para la equidad: viviendo el tejido social en comunidad
En el marco del Día Mundial de las Ciudades, proclamado por la Asamblea General de las Naciones Unidas, Bogotá mostrará al mundo cómo construye tejido social a través de la recuperación de espacios urbanos, la inclusión social y la articulación interinstitucional para llevar al territorio sus servicios de forma oportuna y así transformar la vida de las comunidades.
Recomendaciones para prevenir intoxicaciones, alergias y accidentes durante las festividades de Halloween
El Distrito avanza con operativos de Inspección, Vigilancia y Control (IVC) en 19 localidades de la ciudad, con el fin de prevenir riesgos en la salud de los bogotanos durante las celebraciones de Halloween.
“De la mano contigo” presente en festival “Bebés al Parque”
Bogotá pondrá a disposición de madres y padres de familia, cuidadores y niños y niñas menores de cinco años, la oferta institucional de su estrategia “De la mano contigo”, en el marco del festival «Bebés al Parque». Se trata de una apuesta intersectorial que busca garantizar atención integral y de calidad en educación inicial, salud,...